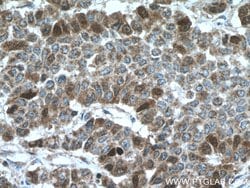
Thymidylate synthase Rabbit anti-Human, Mouse, Rat, Polyclonal, Proteintech

missing translation for 'onlineSavingsMsg'
Learn More
Learn More
Thymidylate synthase Rabbit anti-Human, Mouse, Rat, Polyclonal, Proteintech
Rabbit Polyclonal Antibody
Brand: Proteintech 15047-1-AP-150UL
This item is not returnable.
View return policy
Description
Thymidylate Synthase (TS) (EC 2.1.1.45) converts deoxyuridine monophosphate (dUMP) to deoxythymidine monophosphate (dTMP), which is essential for DNA biosynthesis. TS is a critical target for the fluoropyrimidines, an important group of antineoplastic drugs that are widely used in the treatment of solid tumors. Both 5-FU and fluorodeoxyuridine are converted in tumor cells to FdUMP which inactivates TS by formation of a ternary covalent complex in the presence of the folate cofactor 5,10-methylenetetrahydrofolate. Expression of TS protein is associated with response to 5-fluorouracil (5-FU) in human colorectal, gastric, head and neck, and breast carcinomas.Specifications
| Thymidylate synthase | |
| Polyclonal | |
| Unconjugated | |
| TYMS | |
| HsT422, Thymidylate synthase, thymidylate synthetase, TMS, TS, TSase, TYMS | |
| Rabbit | |
| Antigen Affinity Chromatography | |
| RUO | |
| 22171, 29261, 7298 | |
| -20°C | |
| Liquid |
| Immunocytochemistry, Immunofluorescence, Immunohistochemistry (Paraffin), Immunoprecipitation, Western Blot | |
| 0.31 mg/mL | |
| PBS with 50% glycerol and 0.02% sodium azide; pH 7.3 | |
| P04818, P07607, P45352 | |
| TYMS | |
| Thymidylate synthase Fusion Protein Ag7027 | |
| 150 μL | |
| Primary | |
| Human, Mouse, Rat | |
| Antibody | |
| IgG |
Product Content Correction
Your input is important to us. Please complete this form to provide feedback related to the content on this product.
Product Title
Spot an opportunity for improvement?Share a Content Correction